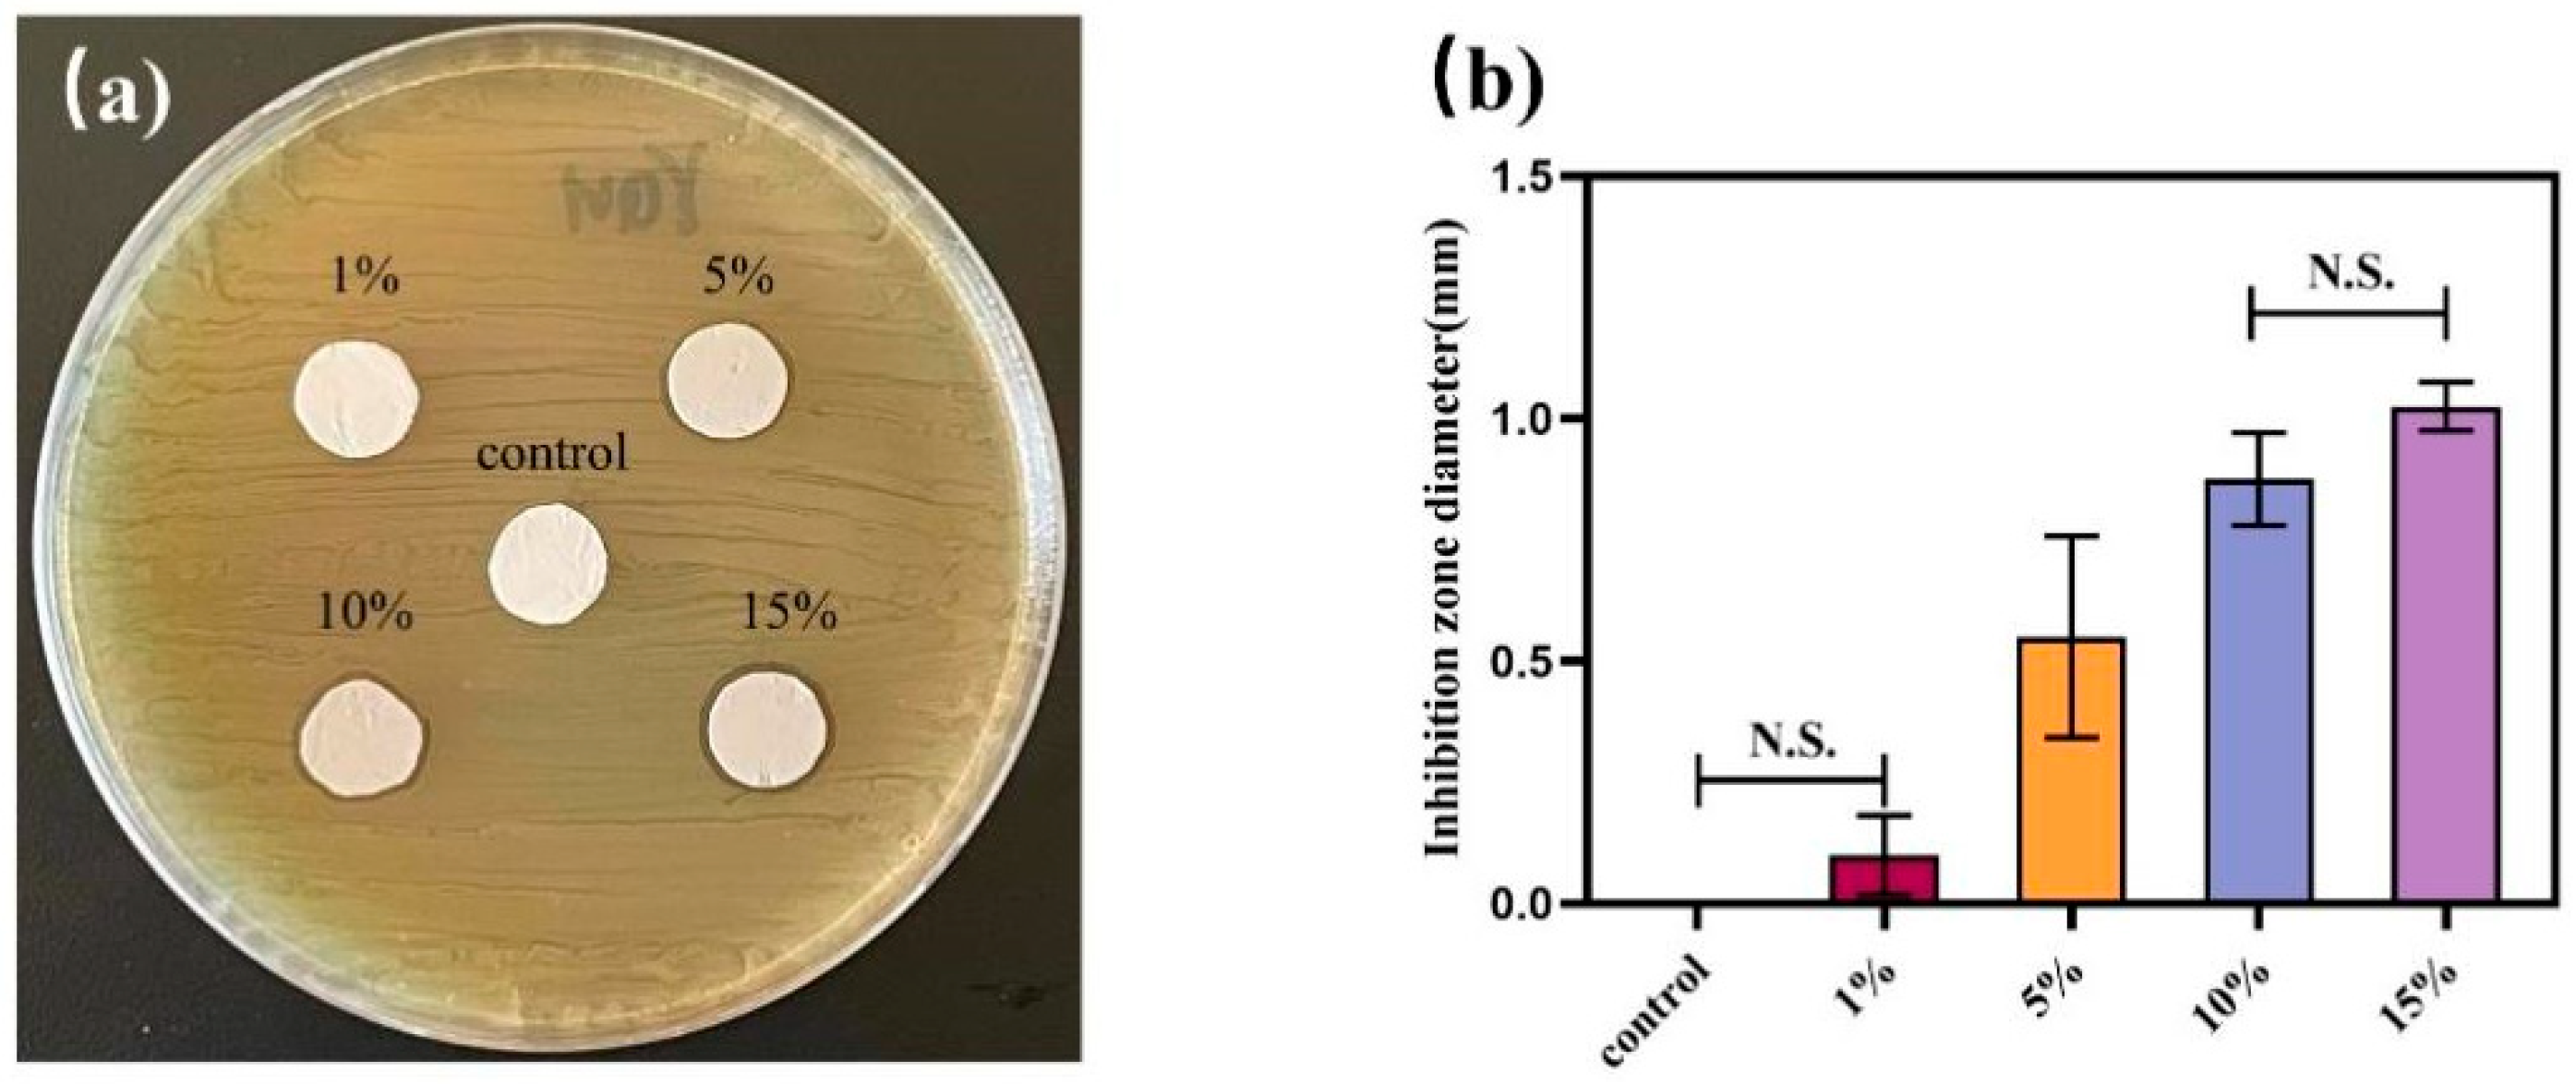
Jfb 13 00303 g004 Jfb 13 00303 g004
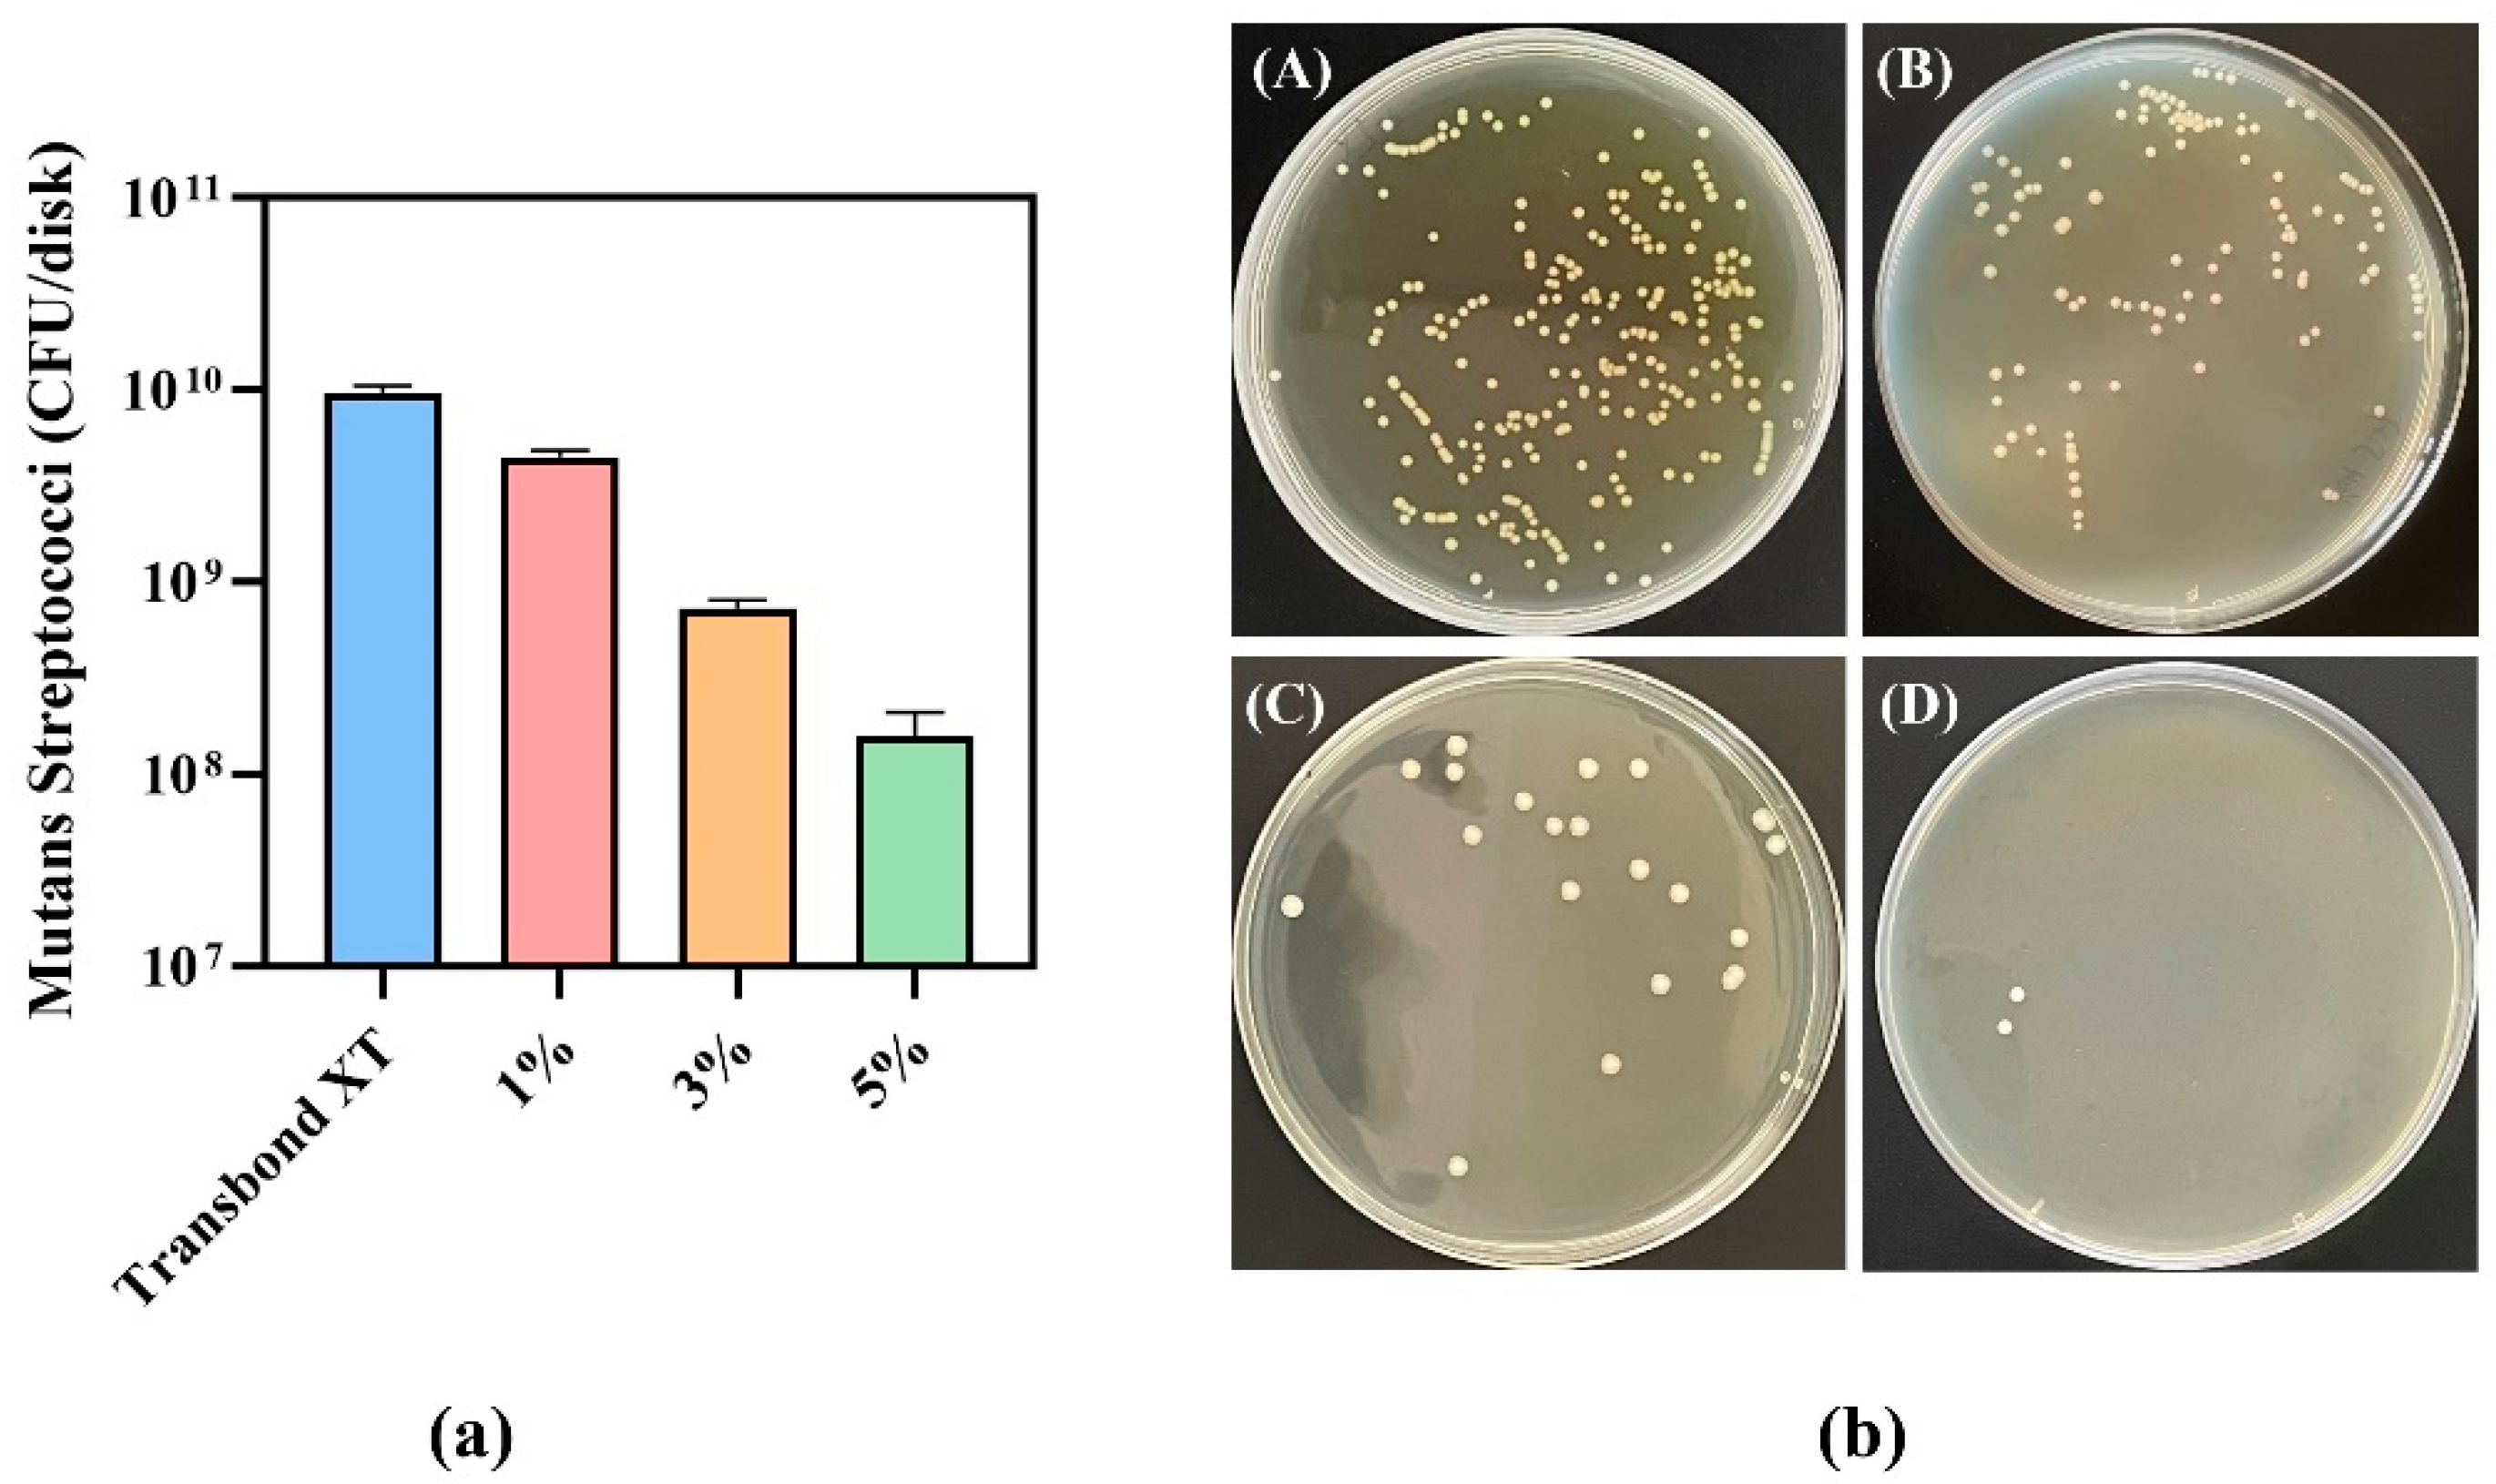
Jfb 13 00303 g006 Jfb 13 00303 g006

Development and Characterization of Novel Orthodontic Adhesive Containing PCL–Gelatin–AgNPs Fibers
Abstract
1. Introduction
2. Materials and Methods
2.1. Preparation of PCL–Gelatin–AgNPs Composite Fibers
2.2. Scanning Electron Microscope (SEM) to Observe the Morphology of Composite Fibers
2.3. X-ray Diffraction Analysis
2.4. Contact Angle Detection
2.5. Agar Diffusion Experiment
2.6. Biocompatibility Testing
2.7. Preparation of Composite Orthodontic Adhesive
2.8. CFU Count
2.9. Bacterial Live/Dead Staining Test
2.10. Adhesive Performance Experiment of Composite Antibacterial Resin Adhesive
2.11. Statistical Analysis
3. Results
3.1. SEM Image of PCL–Gelatin–AgNPs Fibers
3.2. X-ray Diffraction Analysis
3.3. Contact Angle Test
3.4. Agar Diffusion Experiment
3.5. Biocompatibility Testing of Composite Fibers
3.6. CFU Counts of Antibacterial Adhesives
3.7. Bacterial Live/Dead Staining Test
3.8. Adhesive Properties of Antibacterial Adhesives
4. Discussion
5. Conclusions
Author Contributions
Funding
Institutional Review Board Statement
Informed Consent Statement
Data Availability Statement
Conflicts of Interest
References
- Brignardello-Petersen, R. Orthodontic treatment with fixed appliances may result in small clinical attachment level loss. J. Am. Dent. Assoc. 2018, 149, e70. [Google Scholar] [CrossRef]
- Papageorgiou, S.N.; Koletsi, D.; Iliadi, A.; Peltomaki, T.; Eliades, T. Treatment outcome with orthodontic aligners and fixed appliances: A systematic review with meta-analyses. Eur. J. Orthod. 2020, 42, 331–343. [Google Scholar] [CrossRef]
- Fors, R.; Persson, M. Nickel in dental plaque and saliva in patients with and without orthodontic appliances. Eur. J. Orthod. 2006, 28, 292–297. [Google Scholar] [CrossRef] [PubMed]
- Benson, P.E.; Parkin, N.; Dyer, F.; Millett, D.T.; Germain, P. Fluorides for preventing early tooth decay (demineralised lesions) during fixed brace treatment. Cochrane Database Syst. Rev. 2019, 2019, CD003809. [Google Scholar] [CrossRef] [PubMed]
- Ma, Y.; Zhang, N.; Weir, M.D.; Bai, Y.; Xu, H.H.K. Novel multifunctional dental cement to prevent enamel demineralization near orthodontic brackets. J. Dent. 2017, 64, 58–67. [Google Scholar] [CrossRef] [PubMed]
- Lovrov, S.; Hertrich, K.; Hirschfelder, U. Enamel Demineralization during Fixed Orthodontic Treatment—Incidence and Correlation to Various Oral-hygiene Parameters. J. Orofac. Orthop. Fortschr. Kieferorthopadie 2007, 68, 353–363. [Google Scholar] [CrossRef] [PubMed]
- Tasios, T.; Papageorgiou, S.N.; Papadopoulos, M.A.; Tsapas, A.; Haidich, A.B. Prevention of orthodontic enamel demineralization: A systematic review with meta-analyses. Orthod. Craniofacial Res. 2019, 22, 225–235. [Google Scholar] [CrossRef] [PubMed]
- Sondi, I.; Salopek-Sondi, B. Silver nanoparticles as antimicrobial agent: A case study on E. coli as a model for Gram-negative bacteria. J. Colloid Interface Sci. 2004, 275, 177–182. [Google Scholar] [CrossRef] [PubMed]
- Lanteri, V.; Segù, M.; Doldi, J.; Butera, A. Pre-bonding prophylaxis and brackets detachment: An experimental comparison of different methods. Int. J. Clin. Dent. 2014, 7, 191–197. [Google Scholar]
- Lim, B.S.; Lee, S.J.; Lee, J.W.; Ahn, S.J. Quantitative analysis of adhesion of cariogenic streptococci to orthodontic raw materials. Am. J. Orthod. Dentofac. Orthop. 2008, 133, 882–888. [Google Scholar] [CrossRef] [PubMed]
- Sukontapatipark, W.; el-Agroudi, M.A.; Selliseth, N.J.; Thunold, K.; Selvig, K.A. Bacterial colonization associated with fixed orthodontic appliances. A scanning electron microscopy study. Eur. J. Orthod. 2001, 23, 475–484. [Google Scholar] [CrossRef] [PubMed]
- Liu, Y.; Zhang, L.; Niu, L.N.; Yu, T.; Xu, H.H.K.; Weir, M.D.; Oates, T.W.; Tay, F.R.; Chen, J.H. Antibacterial and remineralizing orthodontic adhesive containing quaternary ammonium resin monomer and amorphous calcium phosphate nanoparticles. J. Dent. 2018, 72, 53–63. [Google Scholar] [CrossRef]
- Martini Garcia, I.; Jung Ferreira, C.; de Souza, V.S.; Castelo Branco Leitune, V.; Samuel, S.M.W.; de Souza Balbinot, G.; de Souza da Motta, A.; Visioli, F.; Damiani Scholten, J.; Mezzomo Collares, F. Ionic liquid as antibacterial agent for an experimental orthodontic adhesive. Dent. Mater. 2019, 35, 1155–1165. [Google Scholar] [CrossRef] [PubMed]
- Zaltsman, N.; Kesler Shvero, D.; Polak, D.; Weiss, E.I.; Beyth, N. Antibacterial Orthodontic Adhesive Incorporating Polyethyleneimine Nanoparticles. Oral Health Prev. Dent. 2017, 15, 245–250. [Google Scholar] [CrossRef] [PubMed]
- Yi, J.; Weir, M.D.; Melo, M.A.S.; Li, T.; Lynch, C.D.; Oates, T.W.; Dai, Q.; Zhao, Z.; Xu, H.H.K. Novel rechargeable nano-CaF2 orthodontic cement with high levels of long-term fluoride release. J. Dent. 2019, 90, 103214. [Google Scholar] [CrossRef]
- Zhang, N.; Chen, C.; Weir, M.D.; Bai, Y.; Xu, H.H. Antibacterial and protein-repellent orthodontic cement to combat biofilms and white spot lesions. J. Dent. 2015, 43, 1529–1538. [Google Scholar] [CrossRef]
- Altmann, A.S.; Collares, F.M.; Ogliari, F.A.; Samuel, S.M. Effect of methacrylated-based antibacterial monomer on orthodontic adhesive system properties. Am. J. Orthod. Dentofac. Orthop. 2015, 147, S82–S87. [Google Scholar] [CrossRef] [PubMed]
- Chen, J.; Wang, F.; Liu, Q.; Du, J. Antibacterial polymeric nanostructures for biomedical applications. Chem. Commun. 2014, 50, 14482–14493. [Google Scholar] [CrossRef] [PubMed]
- Ahn, S.J.; Lee, S.J.; Kook, J.K.; Lim, B.S. Experimental antimicrobial orthodontic adhesives using nanofillers and silver nanoparticles. Dent. Mater. 2009, 25, 206–213. [Google Scholar] [CrossRef] [PubMed]
- Degrazia, F.W.; Genari, B.; Leitune, V.C.B.; Arthur, R.A.; Luxan, S.A.; Samuel, S.M.W.; Collares, F.M.; Sauro, S. Polymerisation, antibacterial and bioactivity properties of experimental orthodontic adhesives containing triclosan-loaded halloysite nanotubes. J. Dent. 2018, 69, 77–82. [Google Scholar] [CrossRef]
- Türkün, L.S.; Türkün, M.; Ertuğrul, F.; Ateş, M.; Brugger, S. Long-term antibacterial effects and physical properties of a chlorhexidine-containing glass ionomer cement. J. Esthet. Restor. Dent. 2008, 20, 29–44; discussion 45. [Google Scholar] [CrossRef]
- Liu, D.; Nikoo, M.; Boran, G.; Zhou, P.; Regenstein, J.M. Collagen and gelatin. Annu. Rev. Food Sci. Technol. 2015, 6, 527–557. [Google Scholar] [CrossRef] [PubMed]
- Echave, M.C.; Saenz del Burgo, L.; Pedraz, J.L.; Orive, G. Gelatin as Biomaterial for Tissue Engineering. Curr. Pharm. Des. 2017, 23, 3567–3584. [Google Scholar] [CrossRef] [PubMed]
- Lim, W.L.; Chowdhury, S.R.; Ng, M.H.; Law, J.X. Physicochemical Properties and Biocompatibility of Electrospun Polycaprolactone/Gelatin Nanofibers. Int. J. Environ. Res. Public Health 2021, 18, 4764. [Google Scholar] [CrossRef]
- Cao, S.; Li, L.; Du, Y.; Gan, J.; Wang, J.; Wang, T.; Liu, Y.; Liu, W.; Zhou, Y.; Gao, X.; et al. Porous gelatin microspheres for controlled drug delivery with high hemostatic efficacy. Colloids Surf. B Biointerfaces 2021, 207, 112013. [Google Scholar] [CrossRef] [PubMed]
- Foox, M.; Zilberman, M. Drug delivery from gelatin-based systems. Expert Opin. Drug Deliv. 2015, 12, 1547–1563. [Google Scholar] [CrossRef]
- Sahoo, N.; Sahoo, R.K.; Biswas, N.; Guha, A.; Kuotsu, K. Recent advancement of gelatin nanoparticles in drug and vaccine delivery. Int. J. Biol. Macromol. 2015, 81, 317–331. [Google Scholar] [CrossRef]
- Ravindran, A.; Chandran, P.; Khan, S.S. Biofunctionalized silver nanoparticles: Advances and prospects. Colloids Surf. B Biointerfaces 2013, 105, 342–352. [Google Scholar] [CrossRef]
- Yoshimoto, H.; Shin, Y.M.; Terai, H.; Vacanti, J.P. A biodegradable nanofiber scaffold by electrospinning and its potential for bone tissue engineering. Biomaterials 2003, 24, 2077–2082. [Google Scholar] [CrossRef] [PubMed]
- Chong, E.J.; Phan, T.T.; Lim, I.J.; Zhang, Y.Z.; Bay, B.H.; Ramakrishna, S.; Lim, C.T. Evaluation of electrospun PCL/gelatin nanofibrous scaffold for wound healing and layered dermal reconstitution. Acta Biomater. 2007, 3, 321–330. [Google Scholar] [CrossRef] [PubMed]
- He, C.; Liu, X.; Zhou, Z.; Liu, N.; Ning, X.; Miao, Y.; Long, Y.; Wu, T.; Leng, X. Harnessing biocompatible nanofibers and silver nanoparticles for wound healing: Sandwich wound dressing versus commercial silver sulfadiazine dressing. Mater. Sci. Eng. C Mater. Biol. Appl. 2021, 128, 112342. [Google Scholar] [CrossRef] [PubMed]
- Assad-Loss, T.F.; Vignoli, J.F.; Garcia, I.M.; Portela, M.B.; Schneider, L.F.J.; Collares, F.M.; Cavalcante, L.M.A.; Tostes, M.A. Physicochemical properties and biological effects of quaternary ammonium methacrylates in an experimental adhesive resin for bonding orthodontic brackets. J. Appl. Oral Sci. Rev. FOB 2021, 29, e20201031. [Google Scholar] [CrossRef] [PubMed]
- Xiao, Q.; Zhou, K.; Chen, C.; Jiang, M.; Zhang, Y.; Luo, H.; Zhang, D. Hollow and porous hydroxyapatite microspheres prepared with an O/W emulsion by spray freezing method. Mater. Sci. Eng. C Mater. Biol. Appl. 2016, 69, 1068–1074. [Google Scholar] [CrossRef] [PubMed]
- Si, Y.; Yu, J.; Tang, X.; Ge, J.; Ding, B. Ultralight nanofibre-assembled cellular aerogels with superelasticity and multifunctionality. Nat. Commun. 2014, 5, 5802. [Google Scholar] [CrossRef] [PubMed]
- Mitwalli, H.; Balhaddad, A.A.; AlSahafi, R.; Oates, T.W.; Melo, M.A.S.; Xu, H.H.K.; Weir, M.D. Novel CaF2 Nanocomposites with Antibacterial Function and Fluoride and Calcium Ion Release to Inhibit Oral Biofilm and Protect Teeth. J. Funct. Biomater. 2020, 11, 56. [Google Scholar] [CrossRef] [PubMed]
- Wang, L.; Xie, X.; Li, C.; Liu, H.; Zhang, K.; Zhou, Y.; Chang, X.; Xu, H.H.K. Novel bioactive root canal sealer to inhibit endodontic multispecies biofilms with remineralizing calcium phosphate ions. J. Dent. 2017, 60, 25–35. [Google Scholar] [CrossRef] [PubMed]
- Xie, X.; Wang, L.; Xing, D.; Zhang, K.; Weir, M.D.; Liu, H.; Bai, Y.; Xu, H.H.K. Novel dental adhesive with triple benefits of calcium phosphate recharge, protein-repellent and antibacterial functions. Dent. Mater. 2017, 33, 553–563. [Google Scholar] [CrossRef] [PubMed]
- Li, F.; Li, Z.; Liu, G.; He, H. Long-term antibacterial properties and bond strength of experimental nano silver-containing orthodontic cements. J. Wuhan Univ. Technol.-Mater. Sci. Ed. 2013, 28, 849–855. [Google Scholar] [CrossRef]
- Melo, M.A.; Wu, J.; Weir, M.D.; Xu, H.H. Novel antibacterial orthodontic cement containing quaternary ammonium monomer dimethylaminododecyl methacrylate. J. Dent. 2014, 42, 1193–1201. [Google Scholar] [CrossRef] [PubMed]
- Yu, F.; Dong, Y.; Yu, H.H.; Lin, P.T.; Zhang, L.; Sun, X.; Liu, Y.; Xia, Y.N.; Huang, L.; Chen, J.H. Antibacterial Activity and Bonding Ability of an Orthodontic Adhesive Containing the Antibacterial Monomer 2-Methacryloxylethyl Hexadecyl Methyl Ammonium Bromide. Sci. Rep. 2017, 7, 41787. [Google Scholar] [CrossRef] [PubMed]
- Jatoi, A.W.; Kim, I.S.; Ogasawara, H.; Ni, Q.Q. Characterizations and application of CA/ZnO/AgNP composite nanofibers for sustained antibacterial properties. Mater. Sci. Eng. C Mater. Biol. Appl. 2019, 105, 110077. [Google Scholar] [CrossRef] [PubMed]
- Celebioglu, A.; Aytac, Z.; Umu, O.C.; Dana, A.; Tekinay, T.; Uyar, T. One-step synthesis of size-tunable Ag nanoparticles incorporated in electrospun PVA/cyclodextrin nanofibers. Carbohydr. Polym. 2014, 99, 808–816. [Google Scholar] [CrossRef]
- Salmerón-Valdés, E.N.; Lara-Carrillo, E.; Medina-Solís, C.E.; Robles-Bermeo, N.L.; Scougall-Vilchis, R.J.; Casanova-Rosado, J.F.; Pontigo-Loyola, A.P.; Fernández Barrera, M. Tooth demineralization and associated factors in patients on fixed orthodontic treatment. Scientific reports 2016, 6, 36383. [Google Scholar] [CrossRef] [PubMed]
- Lok, C.N.; Ho, C.M.; Chen, R.; He, Q.Y.; Yu, W.Y.; Sun, H.; Tam, P.K.; Chiu, J.F.; Che, C.M. Proteomic analysis of the mode of antibacterial action of silver nanoparticles. J. Proteome Res. 2006, 5, 916–924. [Google Scholar] [CrossRef] [PubMed]
- Yin, I.X.; Zhao, I.S.; Mei, M.L.; Li, Q.; Yu, O.Y.; Chu, C.H. Use of Silver Nanomaterials for Caries Prevention: A Concise Review. Int. J. Nanomed. 2020, 15, 3181–3191. [Google Scholar] [CrossRef]
- Eslamian, L.; Borzabadi-Farahani, A.; Karimi, S.; Saadat, S.; Badiee, M.R. Evaluation of the Shear Bond Strength and Antibacterial Activity of Orthodontic Adhesive Containing Silver Nanoparticle, an In-Vitro Study. Nanomaterials 2020, 10, 1466. [Google Scholar] [CrossRef] [PubMed]
- Cheng, L.; Weir, M.D.; Xu, H.H.; Antonucci, J.M.; Kraigsley, A.M.; Lin, N.J.; Lin-Gibson, S.; Zhou, X. Antibacterial amorphous calcium phosphate nanocomposites with a quaternary ammonium dimethacrylate and silver nanoparticles. Dent. Mater. 2012, 28, 561–572. [Google Scholar] [CrossRef] [PubMed]
- Cheng, Y.J.; Zeiger, D.N.; Howarter, J.A.; Zhang, X.; Lin, N.J.; Antonucci, J.M.; Lin-Gibson, S. In situ formation of silver nanoparticles in photocrosslinking polymers. J. Biomed. Mater. Res. Part B Appl. Biomater. 2011, 97, 124–131. [Google Scholar] [CrossRef]
- Li, F.; Weir, M.D.; Chen, J.; Xu, H.H. Comparison of quaternary ammonium-containing with nano-silver-containing adhesive in antibacterial properties and cytotoxicity. Dent. Mater. 2013, 29, 450–461. [Google Scholar] [CrossRef]
- Morones, J.R.; Elechiguerra, J.L.; Camacho, A.; Holt, K.; Kouri, J.B.; Ramírez, J.T.; Yacaman, M.J. The bactericidal effect of silver nanoparticles. Nanotechnology 2005, 16, 2346–2353. [Google Scholar] [CrossRef]
- Damm, C.; Münstedt, H.; Rösch, A. Long-term antimicrobial polyamide 6/silver-nanocomposites. J. Mater. Sci. 2007, 42, 6067–6073. [Google Scholar] [CrossRef]
- Yoshida, K.; Tanagawa, M.; Atsuta, M. Characterization and inhibitory effect of antibacterial dental resin composites incorporating silver-supported materials. J. Biomed. Mater. Res. 1999, 47, 516–522. [Google Scholar] [CrossRef]
- Shinya, M.; Shinya, A.; Lassila, L.V.; Gomi, H.; Varrela, J.; Vallittu, P.K.; Shinya, A. Treated enamel surface patterns associated with five orthodontic adhesive systems—surface morphology and shear bond strength. Dent. Mater. J. 2008, 27, 1–6. [Google Scholar] [CrossRef]
- Thomas, R.L.; de Rijk, W.G.; Evans, C.A. Tensile and shear stresses in the orthodontic attachment adhesive layer with 3D finite element analysis. Am. J. Orthod. Dentofac. Orthop. 1999, 116, 530–532. [Google Scholar] [CrossRef] [PubMed]
- Pourhajibagher, M.; Sodagar, A.; Bahador, A. An in vitro evaluation of the effects of nanoparticles on shear bond strength and antimicrobial properties of orthodontic adhesives: A systematic review and meta-analysis study. Int. Orthod. 2020, 18, 203–213. [Google Scholar] [CrossRef] [PubMed]
- Reynolds, I.R. A Review of Direct Orthodontic Bonding. Br. J. Orthod. 1975, 2, 171–178. [Google Scholar] [CrossRef]
- Retief, D.H.; Dreyer, C.J.; Gavron, G. The direct bonding of orthodontic attachments to teeth by means of an epoxy resin adhesive. Am. J. Orthod. 1970, 58, 21–40. [Google Scholar] [CrossRef] [PubMed]
- Cozza, P.; Martucci, L.; De Toffol, L.; Penco, S.I. Shear bond strength of metal brackets on enamel. Angle Orthod. 2006, 76, 851–856. [Google Scholar] [CrossRef] [PubMed]
- Cheng, H.Y.; Chen, C.H.; Li, C.L.; Tsai, H.H.; Chou, T.H.; Wang, W.N. Bond strength of orthodontic light-cured resin-modified glass ionomer cement. Eur. J. Orthod. 2011, 33, 180–184. [Google Scholar] [CrossRef] [PubMed]
- Artun, J.; Bergland, S. Clinical trials with crystal growth conditioning as an alternative to acid-etch enamel pretreatment. Am. J. Orthod. 1984, 85, 333–340. [Google Scholar] [CrossRef]
- Milly, H.; Festy, F.; Watson, T.F.; Thompson, I.; Banerjee, A. Enamel white spot lesions can remineralise using bio-active glass and polyacrylic acid-modified bio-active glass powders. J. Dent. 2014, 42, 158–166. [Google Scholar] [CrossRef] [PubMed]
- Bakry, A.S.; Marghalani, H.Y.; Amin, O.A.; Tagami, J. The effect of a bioglass paste on enamel exposed to erosive challenge. J. Dent. 2014, 42, 1458–1463. [Google Scholar] [CrossRef]
- Bakry, A.S.; Takahashi, H.; Otsuki, M.; Tagami, J. Evaluation of new treatment for incipient enamel demineralization using 45S5 bioglass. Dent. Mater. 2014, 30, 314–320. [Google Scholar] [CrossRef] [PubMed]
- Taha, A.A.; Patel, M.P.; Hill, R.G.; Fleming, P.S. The effect of bioactive glasses on enamel remineralization: A systematic review. J. Dent. 2017, 67, 9–17. [Google Scholar] [CrossRef]
- Scribante, A.; Dermenaki Farahani, M.R.; Marino, G.; Matera, C.; Rodriguez, Y.B.R.; Lanteri, V.; Butera, A. Biomimetic Effect of Nano-Hydroxyapatite in Demineralized Enamel before Orthodontic Bonding of Brackets and Attachments: Visual, Adhesion Strength, and Hardness in In Vitro Tests. BioMed Res. Int. 2020, 2020, 6747498. [Google Scholar] [CrossRef] [PubMed]
- Colombo, M.; Beltrami, R.; Rattalino, D.; Mirando, M.; Chiesa, M.; Poggio, C. Protective effects of a zinc-hydroxyapatite toothpaste on enamel erosion: SEM study. Ann. Stomatol. 2016, 7, 38–45. [Google Scholar] [CrossRef]
- Poggio, C.; Gulino, C.; Mirando, M.; Colombo, M.; Pietrocola, G. Protective effect of zinc-hydroxyapatite toothpastes on enamel erosion: An in vitro study. J. Clin. Exp. Dent. 2017, 9, e118–e122. [Google Scholar] [CrossRef] [PubMed][Green Version]
- Li, Y.; Zhang, D.; Wan, Z.; Yang, X.; Cai, Q. Dental resin composites with improved antibacterial and mineralization properties via incorporating zinc/strontium-doped hydroxyapatite as functional fillers. Biomed. Mater. 2022, 17, 045002. [Google Scholar] [CrossRef]

| Groups | Number | TBS (Mpa) | p Value | |||
|---|---|---|---|---|---|---|
| Mean | Standard Deviation | Min | Max | |||
| Transbond XT | 10 | 10.53 | 1.47 | 8.31 | 12.34 | - |
| Transbond XT + 1% PCL–gel–AgNPs | 10 | 9.95 | 1.09 | 7.95 | 11.50 | 0.674 |
| Transbond XT + 3% PCL–gel–AgNPs | 10 | 9.57 | 1.15 | 7.88 | 11.29 | 0.256 |
| Transbond XT + 5% PCL–gel–AgNPs | 10 | 9.36 | 0.73 | 7.54 | 10.25 | 0.118 |
| Groups | ARI Scores | Statistical Difference | |||
|---|---|---|---|---|---|
| 0 | 1 | 2 | 3 | ||
| Transbond XT | 2 | 3 | 3 | 2 | a |
| Transbond XT + 1% PCL–gel–AgNPs | 0 | 5 | 4 | 1 | a |
| Transbond XT + 3% PCL–gel–AgNPs | 1 | 3 | 5 | 1 | a |
| Transbond XT + 5% PCL–gel–AgNPs | 1 | 3 | 4 | 2 | a |
Publisher’s Note: MDPI stays neutral with regard to jurisdictional claims in published maps and institutional affiliations. |
© 2022 by the authors. Licensee MDPI, Basel, Switzerland. This article is an open access article distributed under the terms and conditions of the Creative Commons Attribution (CC BY) license (https://creativecommons.org/licenses/by/4.0/).
Share and Cite
Yuan, Q.; Zhang, Q.; Xu, X.; Du, Y.; Xu, J.; Song, Y.; Wang, Y. Development and Characterization of Novel Orthodontic Adhesive Containing PCL–Gelatin–AgNPs Fibers. J. Funct. Biomater. 2022, 13, 303. https://doi.org/10.3390/jfb13040303
Yuan Q, Zhang Q, Xu X, Du Y, Xu J, Song Y, Wang Y. Development and Characterization of Novel Orthodontic Adhesive Containing PCL–Gelatin–AgNPs Fibers. Journal of Functional Biomaterials. 2022; 13(4):303. https://doi.org/10.3390/jfb13040303
Chicago/Turabian StyleYuan, Qihan, Qianqian Zhang, Xuecheng Xu, Yuqing Du, Jidong Xu, Yu Song, and Yuanfei Wang. 2022. "Development and Characterization of Novel Orthodontic Adhesive Containing PCL–Gelatin–AgNPs Fibers" Journal of Functional Biomaterials 13, no. 4: 303. https://doi.org/10.3390/jfb13040303
APA StyleYuan, Q., Zhang, Q., Xu, X., Du, Y., Xu, J., Song, Y., & Wang, Y. (2022). Development and Characterization of Novel Orthodontic Adhesive Containing PCL–Gelatin–AgNPs Fibers. Journal of Functional Biomaterials, 13(4), 303. https://doi.org/10.3390/jfb13040303

